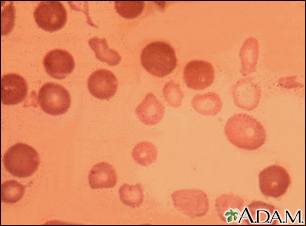

Thalassemia major
Thalassemia major
Thalassemia major is an inherited form of hemolytic anemia, characterized by red blood cell (hemoglobin) production abnormalities. This is the most severe form of anemia, and the oxygen depletion in the body becomes apparent within the first 6 months of life. If left untreated, death usually results within a few years. Note the small, pale (hypochromic), abnormally-shaped red blood cells associated with thalassemia major. The darker cells likely represent normal RBCs from a blood transfusion.

Review Date:1/25/2022
Reviewed By:Todd Gersten, MD, Hematology/Oncology, Florida Cancer Specialists & Research Institute, Wellington, FL. Review provided by VeriMed Healthcare Network. Also reviewed by David Zieve, MD, MHA, Medical Director, Brenda Conaway, Editorial Director, and the A.D.A.M. Editorial team.
The information provided herein should not be used during any medical emergency or for the diagnosis or treatment of any medical condition. A licensed medical professional should be consulted for diagnosis and treatment of any and all medical conditions. Call 911 for all medical emergencies. Links to other sites are provided for information only -- they do not constitute endorsements of those other sites. © 1997-A.D.A.M., Inc. Any duplication or distribution of the information contained herein is strictly prohibited.
The Agency for Health Care Administration (Agency) and this website do not claim the information on, or referred to by, this site is error free. This site may include links to websites of other government agencies or private groups. Our Agency and this website do not control such sites and are not responsible for their content. Reference to or links to any other group, product, service, or information does not mean our Agency or this website approves of that group, product, service, or information.
Additionally, while health information provided through this website may be a valuable resource for the public, it is not designed to offer medical advice. Talk with your doctor about medical care questions you may have.